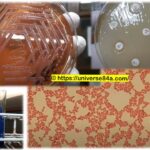
Acinetobacter: Introduction, Morphology, Pathogenicity, Laboratory Diagnosis, Treatment, Prevention, and Keynotes

Tag: Antimicrobial susceptibility testing
Burkholderia: Introduction, Morphology, Pathogenicity, Lab Diagnosis, Treatment, Prevention, and Keynotes
 Introduction Burkholderia is a genus of bacteria that belongs to...
Introduction Burkholderia is a genus of bacteria that belongs to...
Acinetobacter: Introduction, Morphology, Pathogenicity, Laboratory Diagnosis, Treatment, Prevention, and Keynotes
Introduction Acinetobacter is a genus of gram-negative bacteria that includes...
Introduction Acinetobacter is a genus of gram-negative bacteria that includes...
Morganella: Introduction, Morphology, Pathogenicity, Lab Diagnosis, Treatment, Prevention, and Keynotes
 Introduction Morganella is a genus of gram-negative bacteria belonging to...
Introduction Morganella is a genus of gram-negative bacteria belonging to...
